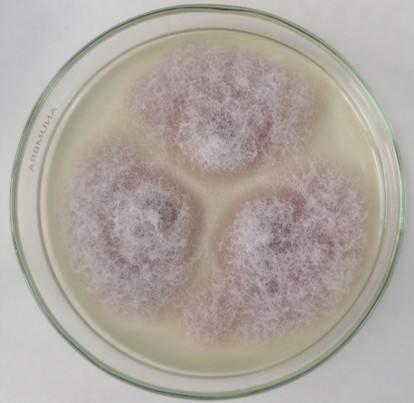
Resim2.jpg

Fusarium proliferatum, Ascomycota şubesine ait, yaygın olarak bitkilerde hastalık oluşturan ve mikotoksin üreten bir mantar türüdür. Bu tür, özellikle mısır, buğday, pirinç, soğan, sarımsak, muz ve hurma gibi birçok tarımsal üründe patojen olarak tanımlanmıştır. Toprakta, bitki kalıntılarında ve tohumlarda saprofit olarak da yaşayabilmektedir. Ayrıca Fusarium proliferatum, insan ve hayvan sağlığını etkileyen toksinler üretebilmesi nedeniyle hem tarımsal hem de halk sağlığı açısından büyük önem taşır.
Morfolojik Özellikler
Laboratuvar koşullarında PDA (Potato Dextrose Agar) veya MEA (Malt Extract Agar) gibi besiyerlerinde hızla gelişir. Kolonileri genellikle beyazdan pembemsi-mor tonlara kadar değişen renklerde olur ve zamanla menekşe veya mor pigmentler salgılar. Mikroskobik olarak, F. proliferatum uzun, ince ve genellikle 3–5 bölmeli (septalı) makrokonidiler üretir. Ayrıca, bol miktarda mikrokonidi ve monofiyalitik konidiyoforlar üretmesiyle karakterizedir. Bu türün ayırt edici morfolojik özelliklerinden biri, dallanan konidiyofor yapısı ve zincir halinde dizilen mikrokonidileridir.
Ekoloji ve Yayılış Alanı
Fusarium proliferatum dünya genelinde tropikal, subtropikal ve ılıman bölgelerde yayılış gösterir. Özellikle nemli ve sıcak ortamlarda hızla çoğalır. Toprak kökenli bir fungus olmasına rağmen, çoğunlukla bitki dokularında endofitik veya patojenik şekilde bulunur. Depolanmış tahıl ürünlerinde de gelişebilir ve bu durum hem ekonomik kayıplara hem de toksik kontaminasyona neden olabilir.
Patojenite ve Konak Aralığı
Bu tür geniş bir konak yelpazesine sahiptir. Mısırda “Fusarium ear rot”, buğdayda “head blight”, soğanda “bulb rot” gibi hastalıklara yol açar. Muz, hurma, üzüm ve domates gibi birçok bitkide kök ve sap çürüklüklerine neden olabilir. İnsanlarda nadiren fırsatçı enfeksiyonlar (örneğin keratit, onikomikoz veya sistemik enfeksiyonlar) bildirilmiştir. Bu nedenle F. proliferatum, hem bitki patojeni hem de potansiyel fırsatçı insan patojeni olarak değerlendirilir.
Mikotoksin Üretimi ve Halk Sağlığı Önemi
Fusarium proliferatum, çeşitli toksijenik sekonder metabolitler üretir. En önemlileri fusaric asit, fumonisinler (özellikle B₁, B₂, B₃), beauvericin, ve moniliformin’dir. Bu toksinler karaciğer, böbrek ve sinir sisteminde hasara yol açabilir. Fumonisin B₁ özellikle kanserojen potansiyele sahiptir ve gıda güvenliği açısından ciddi bir tehdit oluşturur. Avrupa Birliği ve Dünya Sağlık Örgütü, fumonisinlerin tahıl ürünlerindeki miktarına sınır getirmiştir.
Endüstriyel ve Biyoteknolojik Önemi
Her ne kadar çoğunlukla zararlı bir tür olarak bilinse de, Fusarium proliferatum bazı enzimlerin ve sekonder metabolitlerin üretiminde biyoteknolojik olarak değerlendirilmektedir. Özellikle lignoselülotik enzimlerin (örneğin selülaz, ksilanaz) üretimi açısından potansiyele sahiptir. Ayrıca biyokontrol ve biyoremediasyon çalışmaları kapsamında toksin üretmeyen suşları üzerine araştırmalar yürütülmektedir.
Kontrol ve Mücadele Yöntemleri
Hastalığın kontrolü zor olmakla birlikte, kültürel önlemler (ürün rotasyonu, temiz tohum kullanımı, uygun depolama koşulları) en etkili yöntemlerdir. Kimyasal fungisitler genellikle sınırlı etkiye sahiptir. Günümüzde biyolojik mücadele ajanları (örneğin Trichoderma türleri) ve mikotoksin üretimini baskılayan doğal bileşikler üzerine araştırmalar devam etmektedir.